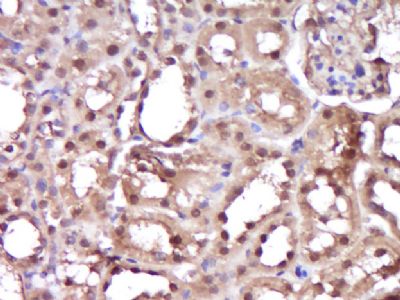
产品细节图片2

相关产品推荐更多 >
万千商家帮你免费找货
0 人在求购买到急需产品
- 详细信息
- 文献和实验
- 技术资料
- 供应商:
上海联迈生物工程有限公司
- 库存:
大量
- 目录编号:
LM-20399R
- 克隆性:
多克隆
- 抗原来源:
Rabbit
- 保质期:
1年
- 抗体英文名:
HIF-1 Alpha
- 抗体名:
缺氧诱导因子1α /HIF-1α抗体
- 宿主:
Rabbit
- 适应物种:
Human, Mouse, Rat, Chicken,
- 免疫原:
KLH conjugated synthetic peptide derived from human HIF-1 Alpha:661-760/826
- 亚型:
IgG
- 形态:
Lyophilized or Liquid
- 应用范围:
WB=1:500-2000 ELISA=1:500-1000 IHC-P=1:400-800 IHC-F=1:400-800 Flow-Cyt=1μg/Test ICC=1:100-500 IF=1:100-500 (石蜡切片需做抗原修复)
- 浓度:
1mg/ml
- 保存条件:
Store at -20 °C
- 规格:
100ul 200ul
| 英文名称 | HIF-1 Alpha |
| 中文名称 | 缺氧诱导因子1α /HIF-1α抗体 |
| 别 名 | ARNT interacting protein; ARNT-interacting protein; Basic helix loop helix PAS protein MOP1; Basic-helix-loop-helix-PAS protein MOP1; bHLHe78; Class E basic helix-loop-helix protein 78; HIF 1A; HIF 1alpha; HIF-1-alpha; HIF1 A; HIF1 Alpha; HIF1; HIF1-alpha; HIF1A; HIF1A_HUMAN; Hypoxia inducible factor 1 alpha; Hypoxia inducible factor 1 alpha isoform I.3; Hypoxia inducible factor 1 alpha subunit; Hypoxia inducible factor 1 alpha subunit basic helix loop helix transcription factor; Hypoxia inducible factor 1, alpha subunit (basic helix loop helix transcription factor); Hypoxia inducible factor1alpha; Hypoxia-inducible factor 1-alpha; Hypoxia-inducible factor-1a; Member of PAS protein 1; Member of PAS superfamily 1; Member of the PAS Superfamily 1; MOP 1; MOP1; PAS domain-containing protein 8; PASD 8; PASD8. |
| 规格价格 | 100ul/1380元 购买 200ul/2200元 购买 大包装/询价 |
| 说 明 书 | 100ul 200ul |
| 研究领域 | 肿瘤 细胞生物 神经生物学 信号转导 细胞凋亡 |
| 抗体来源 | Rabbit |
| 克隆类型 | Polyclonal |
| 交叉反应 | Human, Mouse, Rat, Chicken, |
| 产品应用 | WB=1:500-2000 ELISA=1:500-1000 IHC-P=1:400-800 IHC-F=1:400-800 Flow-Cyt=1μg/Test ICC=1:100-500 IF=1:100-500 (石蜡切片需做抗原修复) not yet tested in other applications. optimal dilutions/concentrations should be determined by the end user. |
| 分 子 量 | 92kDa |
| 细胞定位 | 细胞核 细胞浆 |
| 性 状 | Lyophilized or Liquid |
| 浓 度 | 1mg/ml |
| 免 疫 原 | KLH conjugated synthetic peptide derived from human HIF-1 Alpha:661-760/826 |
| 亚 型 | IgG |
| 纯化方法 | affinity purified by Protein A |
| 储 存 液 | Preservative: 15mM Sodium Azide, Constituents: 1% BSA, 0.01M PBS, pH 7.4 |
| 保存条件 | Store at -20 °C for one year. Avoid repeated freeze/thaw cycles. The lyophilized antibody is stable at room temperature for at least one month and for greater than a year when kept at -20°C. When reconstituted in sterile pH 7.4 0.01M PBS or diluent of antibody the antibody is stable for at least two weeks at 2-4 °C. |
| PubMed | PubMed |
| 产品介绍 | background: Hypoxia-inducible factor-1 (HIF1) is a transcription factor found in mammalian cells cultured under reduced oxygen tension that plays an essential role in cellular and systemic homeostatic responses to hypoxia. HIF1 is a heterodimer composed of an alpha subunit and a beta subunit. The beta subunit has been identified as the aryl hydrocarbon receptor nuclear translocator(ARNT). This gene encodes the alpha subunit of HIF-1. Overexpression of a natural antisense transcript (aHIF) of this gene has been shown to be associated with nonpapillary renal carcinomas. Two alternative transcripts encoding different isoforms have been identified. Function: Functions as a master transcriptional regulator of theadaptive response to hypoxia. Under hypoxic conditions activatesthe transcription of over 40 genes, including, erythropoietin,glucose transporters, glycolytic enzymes, vascular endothelialgrowth factor, and other genes whose protein products increaseoxygen delivery or facilitate metabolic adaptation to hypoxia.Plays an essential role in embryonic vascularization, tumorangiogenesis and pathophysiology of ischemic disease. Binds to coreDNA sequence 5'-[AG]CGTG-3' within the hypoxia response element(HRE) of target gene promoters. Activation requires recruitment oftranscriptional coactivators such as CREBPB and EP300. Activity isenhanced by interaction with both, NCOA1 or NCOA2. Interaction withredox regulatory protein APEX seems to activate CTAD andpotentiates activation by NCOA1 and CREBBP. Subunit: Interacts with COPS5 subunit of COP9 signalosome complex,leading to the regulation of its stability. Interacts with TSGA10(By similarity). Efficient DNA binding requires heterodimerizationof an alpha and a beta/ARNT subunit. Binds to the TAZ-type 1domains of CREBBP and EP300. Interacts with NCOA1, NCOA2, APEX andHSP90. Interacts with VHL which docks HFA1 to the E3 ubiquitinligase complex for subsequent destruction. Interaction, via the ODDdomain, with the beta domain of VHLL, protects HIF1A fromdestruction by competing against the destructive targetinginitiated by VHL. Subcellular Location: Cytoplasm. Nucleus. Tissue Specificity: Expressed in most tissues with highest levels in kidney and heart. Overexpressed in the majority of common human cancers and their metastases, due to the presence of intratumoral hypoxia and as a result of mutations in genes encoding oncoproteins and tumor suppressors. Post-translational modifications: In normoxia, is hydroxylated on Pro-402 and Pro-564 in theoxygen-dependent degradation domain (ODD) by EGLN1/PHD1 andEGLN2/PHD2. EGLN3/PHD3 has also been shown to hydroxylate Pro-564.The hydroxylated prolines promote interaction with VHL, initiatingrapid ubiquitination and subsequent proteasomal degradation. Underhypoxia, proline hydroxylation is impaired and ubiquitination isattenuated, resulting in stabilization. In normoxia, is hydroxylated on Asn-803 by HIF1AN, thusabrogating interaction with CREBBP and EP300 and preventingtranscriptional activation. S-nitrosylation of Cys-800 may be responsible for increasedrecruitment of p300 coactivator necessary for transcriptionalactivity of HIF-1 complex. Acetylation of Lys-532 by ARD1 increases interaction with VHLand stimulates subsequent proteasomal degradation. Requires phosphorylation for DNA-binding. Similarity: Contains 1 basic helix-loop-helix (bHLH) domain. Contains 1 PAC (PAS-associated C-terminal) domain. Contains 2 PAS (PER-ARNT-SIM) domains. SWISS: Q16665 Gene ID: 3091 Database links: Entrez Gene: 3091 Human Entrez Gene: 15251 Mouse Omim: 603348 Human SwissProt: Q16665 Human SwissProt: Q61221 Mouse Unigene: 597216 Human Unigene: 3879 Mouse Unigene: 446610 Mouse
Important Note: This product as supplied is intended for research use only, not for use in human, therapeutic or diagnostic applications. 缺氧诱导因子1α不仅对于机体在缺氧条件下维持正常的生理功能具有特别重要的意义,并在肿瘤的生长以及神经细胞凋亡等病理过程中起重要作用. HIF1 alpha能调节许多下游基因的表达水平. 哺乳动物细胞在低氧压力条件下出现HIF。HIF是一种转录因子,对细胞的缺氧起稳定作用。 |
| 产品图片 |  Sample: 1. A549 Cell (Human) Lysate at 40 ug 2. Hela Cell (Human) Lysate at 40 ug 3. Kidney (Mouse) Lysate at 40 ug 4. Heart (Mouse) Lysate at 40 ug 5. MCF-7 Cell (Human) Lysate at 40 ug 6. HL60 Cell (Human) Lysate at 40 ug 7. Ht1080 Cell (Human) Lysate at 40 ug Primary: Anti- HIF-1 alpha (bs-20399R) at 1/300 dilution Secondary: IRDye800CW Goat Anti-Rabbit IgG at 1/20000 dilution Predicted band size: 92 kD Observed band size: 100 kD-135kD Paraformaldehyde-fixed, paraffin embedded (Rat kidney); Antigen retrieval by boiling in sodium citrate buffer (pH6.0) for 15min; Block endogenous peroxidase by 3% hydrogen peroxide for 20 minutes; Blocking buffer (normal goat serum) at 37°C for 30min; Antibody incubation with (HIF-1 Alpha) Polyclonal Antibody, Unconjugated (bs-20399R) at 1:400 overnight at 4°C, followed by operating according to SP Kit(Rabbit) (sp-0023) instructions and DAB staining.  Blank control (blue line): Hela (fixed with 80% methanol (5 min at -20℃) and then permeabilized with 0.1% PBS-Tween for 20 min at room temperature). Primary Antibody (green line): Rabbit Anti- HIF-1 Alpha antibody (bs-20399R), Dilution: 1μg /10^6 cells; Isotype Control Antibody (orange line): Rabbit IgG . Secondary Antibody (white blue line): Goat anti-rabbit IgG-FITC,Dilution: 1μg /test. |
风险提示:丁香通仅作为第三方平台,为商家信息发布提供平台空间。用户咨询产品时请注意保护个人信息及财产安全,合理判断,谨慎选购商品,商家和用户对交易行为负责。对于医疗器械类产品,请先查证核实企业经营资质和医疗器械产品注册证情况。
 文献和实验
文献和实验人低氧诱导因子-1α(HIF-1α)酶联免疫分析(ELISA)
人 低氧诱导因子-1α(HIF-1α) 酶联免疫 分析( ELISA ) 试剂 盒使用说明书 本试剂仅供研究使用 目的:本试剂盒用于测定人血清,血浆及相关液体样本中 低氧诱导因子-1α(HIF-1α)的 含量。 实验原理 : 本试剂盒应用双抗体夹心法测定 标本 中 人 低氧诱导因子-1 α( HIF-1 α) 水平。用纯化的 人 低氧诱导因子-1 α( HIF-1 α) 抗体包被微孔板,制成固相抗体,往包
人缺氧诱导因子-1a(HIF-1a)ELISA试剂盒 说明书
上海西唐生物科技有限公司 021-55229872, 65333639 www.westang.com 人缺氧诱导因子-1 a ( HIF-1 a )ELISA 试剂盒 ( 用于血清、血浆、细胞培养上清液和其它生物体液内 ) 原理 本实验采用双抗体夹心 ABC-ELISA 法。用抗人 HIF-1 a 单抗包被于酶标板上,标准品和样品中的 HIF-1 a 与单抗结合
大鼠缺氧诱导因子-1a(HIF-1a)ELISA试剂盒 说明书
上海西唐生物科技有限公司 021-55229872, 65333639 www.westang.com 大鼠缺氧诱导因子 -1 a (HIF-1 a )ELISA 试剂盒 ( 用于血清、血浆、细胞培养上清液和其它生物体液内 ) 原理 本实验采用双抗体夹心 ABC-ELISA 法。用抗大鼠 HIF-1 a 单抗包被于酶标板上,标准品和样品中的 HIF-1 a 与单抗结合,加入生物素化的抗大鼠 HIF
 技术资料
技术资料暂无技术资料 索取技术资料










